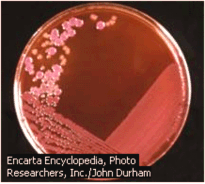
a b c Hình 6 2 a Các khuẩn lạc E coli sinh trưởng trên đĩa thạch agar b Hai dạng 1

Trước khi tìm hiểu các cơ chế nói trên chúng ta hãy xem xét cách sinh trưởng của vi khuẩn trên đối tượng E. coli và nguyên tắc nghiên cứu di truyền học đối với vi khuẩn.
Xung quanh chúng ta vi khuẩn có mặt hầu như khắp nơi. Trong những điều kiện sinh trưởng thuận lợi nhất định, một vi khuẩn nhanh chóng lớn lên hay dài ra và phân chia (trực phân) tạo thành hai tế bào con có vật chất di truyền giống như tế bào cha mẹ. Nếu như môi trường cực thuận, E. coli có thể phân chia trung bình cứ 20 phút mỗi thế hệ, và chẳng mấy chốc bề mặt trái đất phủ đầy các vi khuẩn. Nhưng thực tế lại không như thế. Lý do chủ yếu là các điều kiện cực thuận là rất hiếm hoi!
I. Làm việc với các vi khuẩn
Các nhà khoa học nghiên cứu vi khuẩn cố gắng tạo ra môi trường nuôi cấy cực thuận trong phòng thí nghiệm, với nguồn năng lượng thiết yếu, các chất dinh dưỡng, pH và nhiệt độ mà khả năng sinh trưởng của vi khuẩn có thể dự đoán được.
(a) (b) (c)
Hình 6.2 (a) Các khuẩn lạc E. coli sinh trưởng trên đĩa thạch agar. (b) Hai dạng khuẩn lạc nhẵn và thô nhám - trên và dưới - của S. pneumoniae; và (c) phương pháp thu nhận bản sao các khuẩn lạc qua đêm sinh trưởng trên môi trường đặc hiệu: các khuẩn lạc mọc được có màu xanh và không mọc được màu trắng.
Vi khuẩn có thể được nuôi cấy trên môi trường đặc (thường chứa thạch agar) hoặc trong môi trường lỏng. Trong môi trường lỏng, vi khuẩn sinh sản theo hàm số mũ cho đến khi hết chất dinh dưỡng hoặc cho đến khi tích luỹ những sản phẩm độc hại. Số lượng vi khuẩn tồn tại ở mỗi thời điểm trong môi trường lỏng có thể xác định được một cách dễ dàng. Dùng pipet đưa một mẫu nhỏ lên đĩa petri có môi trường đặc rồi cấy chải đều trên mặt thạch. Sau thời gian ủ 24 - 36 giờ mỗi tế bào vi khuẩn sẽ cho một cụm tế bào có thể dễ dàng nhìn thấy được bằng mắt thường gọi là khuẩn lạc (colonies; Hình 6.2a) chứa hàng triệu tế bào, ngay cả trong những điều
kiện sinh trưởng tương đối nghèo nàn. Do đó, các thí nghiệm ở E. coli thường chỉ mất một ngày, trong khi ở ngô chẳng hạn phải mất hàng tháng.. Khả năng mọc hay không mọc của vi khuẩn trên những môi trường riêng biệt giúp ta xác định kiểu gene của tế bào vi khuẩn (Hình 6.2c).
Các vi khuẩn thường trải qua các pha sinh trưởng trong môi trường nuôi cấy huyền phù như sau (xem Hình 6.3A):
(i) Pha lag: Sinh trưởng thoạt đầu rất chậm, vì chúng phải làm quen với đời sống trong các điều kiện mới.
(ii) Pha log (logarithmic hay exponential): Một khi bộ máy chuyển hoá vận hành, chúng bắt đầu phân chia theo hàm số mũ, gấp đôi số lượng sau vài phút:
.
(iii) Pha dừng (stationary): Khi môi trường sống cạn kiệt, sự sinh trưởng vi khuẩn dừng lại và ổn định về số lượng. Và, cuối cùng,
(iv) Pha chết (death): Các sản phẩm độc do bài tiết tích luỹ có thể gây chết vi khuẩn.


Hình 6.3A Các tế bào vi khuẩn E. coli đang phân chia (bên trái), và đường cong sinh trưởng của vi khuẩn trong dịch huyền phù (bênphải; trục tung biểu thị số tế bào tăng theo hàm số mũ, và trục hoành biểu thị thời gian).
Đã nhiều lần các nhà nghiên cứu muốn xác định xem bằng cách nào các tế bào phân chia hay sinh trưởng một cách nhanh chóng như vậy. Một phương pháp đơn giản để đo tốc độ sinh trưởng là đếm số tế bào trong một đơn vị thể tích nhỏ (aliquot) tại nhiều thời điểm và biểu diễn một đường cong sinh trưởng (growth curve; Hình 6.3B). Đó là một đường cong không quá cong lắm như như đồ thị về số lượng tế bào (number of cells) đếm được tại các thời điểm khác nhau. Nếu như các tế bào có được không gian và dưỡng chất không giới hạn, thì chúng sẽ sinh trưởng ở tốc độ hàm số mũ. Như chỉ ra ở Hình 6.3B, cùng các số liệu về đường cong sinh trưởng như nhau được phác hoạ trên một thang tuyến tính (linear scale) hay thang log (log scale).
Mặc dù các tế bào có thể sinh trưởng một cách vô hạn trong một không gian nào đó, nhưng các phòng thí nghiệm thì không thể làm được những cái lọ to quá
cỡ. Vì vậy các tế bào thường được cho sinh trưởng trong các môi trường pha loãng. Chẳng hạn, thử hình dung 1.000 tế bào được cho vào trong một cái lọ và sau đó có 1.000.000 tế bào dược sinh ra trong đó. Nếu mất độ tế bào quá dày đặc, thì chúng sẽ sinh trưởng chậm lại. Để ngăn chặn sự suy giảm các tế bào, thì một phần mẫu đại diện của các tế bào (ví dụ, một mL chứa 1.000 tế bào) sẽ được chuyển sang một lọ mới và sẽ sinh trưởng. Quá trình lấy một số tế bào từ lọ này và cho sinh trưởng tiếp tục trong một lọ mới cho đến khi nhà nghiên cứu có đủ số lượng tế bào để tiến hành thí nghiệm.
Có nhiều cách khác nhau để đo ttốc độ sinh trưởng. Đôi khi, người ta bổ sung các dNTP có đánh dấu đồng vị phóng xạ (radioactive) vào môi trường nuôi cấy các tế bào. Khi các tế bào tái bản các DNA của chúng, chúng sẽ kết hợp các dNTP vào trong DNA của chúng và qua đó có thể định lượng được. Phương pháp tái bản DNA này thường được dùng để dành các mẫu mô sống hoặc các tế bào eukaryote được cho sinh trưởng trong các đĩa nuôi cấy. Các vi khuẩn, nấm men và nhiều vi sinh vật khác thường được đếm một cách trực tiếp.


Hình 6.3 Các đường cong sinh trưởng. Đồ thị bên trái cho thấy tốc độ sinh trưởng được biểu thị bằng các chấm trên một thang tuyến tính. Đồ thị bên phải cho thấy cùng số liệu đó trên thang logarith.
1. Các thể đột biến của vi khuẩn
Để phân tích di truyền ở vi khuẩn thường dùng các thể đột biến sau :
(i) Đột biến khuyết dưỡng (auxotroph): Các thể đột biến không có khả năng tổng hợp chất cần thiết như kiểu dại (hay thể nguyên dưỡng, prototroph) và do đó, không sinh trưởng được nếu không thêm vào môi trường chất dinh dưỡng đó. Ví dụ, thể đột biến khuyết dưỡng methionin không sống được trên môi trường chỉ chứa muối vô cơ (môi trường tối thiểu, minimal medium) nhưng nếu thêm methionin vào thì nó sống được.
(ii) Đột biến kháng chất kháng sinh: Những đột biến này có thể sinh trưởng được khi có chất kháng sinh trong môi trường, như streptomycin
(str) hay tetracyclin (tet). Ví dụ, tế bào mẫn cảm với streptomycin (Strs)là kiểu dại và không mọc trên môi trường có streptomycin nhưng những thể đột biến kháng streptomycin (Strr) lại mọc được.
(iii) Đột biến nguồn carbon: Các thể đột biến này không sử dụng được một cơ chất nào đó làm nguồn năng lượng hay nguồn cung cấp carbon. Ví dụ, thể đột biến lac- không sử dụng đường lactose.
Môi trường mà trên đó mọi vi khuẩn đều mọc được được gọi là môi trường không chọn lọc. Nếu môi trường chỉ cho một kiểu tế bào mọc được, thì gọi là môi trường chọn lọc. Ví dụ, môi trường chứa streptomycin là chọn lọc cho thể đột biến Strr và môi trường tối thiểu chứa lactose là chọn lọc cho Lac+. Để lai vi khuẩn người ta trộn hai thể đột biến khuyết dưỡng khác nhau với nhau, chẳng hạn a b c d+ e+ f+ và a+ b+ c+ d e f, rồi đem cấy hỗn hợp lai lên môi trường tối thiểu, các tế bào nào mọc được trên môi trường này chính là các tế bào lai nguyên dưỡng (a+ b+ c+ d+ e+ f+).
2. Kiểu hình và kiểu gene của vi khuẩn
Trong di truyền học vi khuẩn, kiểu gene và kiểu hình được ký hiệu như sau: (i). Kiểu gene: Các gene vi khuẩn được đặt tên bằng cách sử dụng danh pháp di truyền tiêu chuẩn do Demerec đề nghị. Mỗi gene được ký hiệu bằng chữ cái thường in nghiêng, và dấu (+) hay (-) để chỉ có mang hay không mang tính trạng nào đó, hoặc "s" hay "r" để chỉ tính mẫn cảm hay kháng với chất nào đó. (ii) Kiểu hình được ký hiệu bằng ba chữ cái với ký hiệu như kiểu gene nhưng với chữ cái đầu viết hoa.(xem Bảng 6.1).
Bảng 6.1 Một số ký hiệu kiểu gene và kiểu hình của di truyền học vi khuẩn
Ký hiệu
Kiểu hình | Mô tả kiểu hình | |
lac- | Lac- | Không thể chuyển hoá đường lactose |
mal- | Mal- | Không thể chuyển hoá đường maltose |
ara- | Ara- | Không thể chuyển hoá đường arabinose |
trp- | Trp- | Không thể tạo ra amino acid tryptophan |
pro- | Pro- | Không thể tạo ra amino acid proline |
leu- | Leu- | Không thể tạo ra amino acid leucine |
bio- | Bio- | Không thể tạo ra vitamin biotin |
tonr | Tonr | Kháng được phage T1 |
tons | Tons | Có thể bị lây nhiễm bởi phage T1 |
strr | Strr | Kháng được chất kháng sinh streptomycin |
strs | Strs | Mẫn cảm với chất kháng sinh streptomycin |
Có thể bạn quan tâm!
-
Tính Đa Dạng Về Cấu Trúc Và Thành Phần Di Truyền -
Đột Biến Mất Đoạn Được Sử Dụng Để Chia Locus Rii Của Bacteriophage T4 Thành 7 Vùng Và 47 Tiểu Vùng Nhỏ -
Các Vùng Chức Năng Của Phân Tử Rna Viroid -
Sự Xen Plasmid F Vào Trong Nhiễm Sắc Thể Vật Chủ -
Lập Bản Đồ Với E. Coli: Các Plasmid F' Và Trắc Nghiệm Cis-Trans -
Phân Tích Di Truyền Trong Chu Trình Cận Hữu Tính (Tái Tổ Hợp Trong Nguyên Phân)
Xem toàn bộ 226 trang tài liệu này.
II. Biến nạp ở vi khuẩn (Transformation)
Lần đầu tiên tái tổ hợp di truyền ở E. coli được phát hiện trong các thí nghiệm của Joshua Lederberg và E.L. Tatum năm 1946. Nhưng cơ sở của hiện tượng này được giải thích trong công trình của Wollman và Jacob nămh 1955 về sự tiếp hợp ở E. coli. Đến nay, tái tổ hợp di truyền ở vi khuẩn được nghiên cứu kỹ trong ba phương thức đã nói ở trên: biến nạp, tiếp hợp và tải nạp; trong đó vật chất di truyền (một phần của bộ gene hoặc plasmid) được truyền từ tế bào này (thể cho, donor) sang tế bào khác (thể nhận, recipient) theo cách thức khác nhau. Trước tiên, ta hãy xét quá trình biến nạp vốn được ghi nhận rất sớm bởi Griffith từ năm 1928.
1. Định nghĩa, thí nghiệm và đặc điểm chung
Biến nạp là quá trình xâm nhập của DNA ngoại bào (thể cho) vào tế bào thể nhận và gây biến đổi một (một số) đặc tính của thể nhận bằng ảnh hưởng của DNA thể cho. Khác với tiếp hợp và tải nạp, biến nạp là quá trình chuyển DNA trực tiếp tách ra từ thể cho sang thể nhận mà không cần sự tiếp xúc trực tiếp giữa hai tế bào hoặc thông qua vật trung gian (các phage). Tế bào thể cho và thể nhận có thể bắt nguồn từ các sinh vật khác nhau, nhưng trong khuôn khổ của chương này, chúng ta chỉ xét hiện tượng biến nạp ở vi khuẩn. Hiện tượng này lần đầu tiên được Fred Griffith phát hiện ở vi khuẩn Streptococcus pneumoniae năm 1928 trong các thí nghiệm trên chuột. Tiếp tục phát triển hướng nghiên cứu này với DNA tinh chiết và gây biến nạp in vitro, thông qua xử lý bằng các enzyme khác nhau, đến năm 1944 O.T. Avery và cs đã chứng minh được rằng: DNA là vật chất mang thông tin di truyền, chứ không phải protein.
2. Cơ chế phân tử của biến nạp
Cơ chế biến nạp chủ yếu bao gồm việc vi khuẩn thể nhận tiếp nhận DNA của thể cho (gọi là đoạn ngoại lai, exogenote) và sau đó DNA này có thể trao đổi với đoạn DNA tương đồng của thể nhận (gọi là đoạn nội tại, endogenote) bằng trao đổi chéo. Những tế bào có khả năng tiếp nhận DNA gọi là các tế bào khả biến (competent). Tế bào vi khuẩn nhận đoạn ngoại lai lúc đó có bộ gene ở trạng thái lưỡng bội một phần (merodiploid) hay hợp tử từng phần (merozygote). Quá trình trao đổi thông tin di truyền bằng cách chuyển chỉ một phần vật chất di truyền như thế được gọi là sự giao nạp hay tiếp hợp từng phần (meromixis).
Tương tự như trong tiếp hợp và tải nạp, để lập bản đồ di truyền bằng biến nạp cần có các tế bào thể cho và thể nhận có các kiểu gene khác nhau. Về mặt thực nghiệm, DNA được tách ra từ các tế bào thể cho, sau đó được đưa vào quần thể các thể bào thể nhận. Các tế bào thể nhận sẽ tiếp nhận các đoạn DNA một cách ngẫu nhiên. Không phải tất cả các loài vi khuẩn
đều có khả năng tiếp nhận DNA. Ngay cả những loài có khả năng này cũng chỉ có thể tiếp nhận được DNA ở những pha sinh trưởng nhất định và trong môi trường nuôi cấy cụ thể. Các loài Streptoccocus pneumoniae (tức Diplococcus) và Bacillus subtilis tương đối dễ dàng trở thành khả biến hơn, trong khi E. coli phải mất đi hai loại enzyme exonuclease và phải được nuôi cấy trong môi trường có nồng độ cao của calcium chloride để làm cho màng tế bào của nó có thể thấm được DNA. Do vậy để lập bản đồ gene ở E. coli người ta ưa dùng tiếp hợp và tải nạp hơn. Tuy nhiên, trong công nghệ DNA tái tổ hợp, biến nạp E. coli là một khâu rất quan trọng (chương 8).
Để biến nạp có thể xảy ra với hiệu quả cao ở vi khuẩn, chẳng hạn B. subtilis, DNA biến nạp phải có mạch kép và phân tử lượng tương đối cao (1.106 dalton). Khi DNA xuyên qua màng tế bào của vi khuẩn khả biến thì một trong các sợi của DNA bị phân huỷ. Sau đó sợi đơn DNA chuyển sang có thể trao đổi với nhiễm sắc thể thể nhận ở vùng tương đồng; sự kiện này có thể phát hiện được nhờ những khác biệt di truyền thích hợp giữa các tế bào thể cho và thể nhận.
Tóm lại, hiệu quả của biến nạp phụ thuộc vào ba yếu tố: (i) Tính dung nạp hay khả biến của tế bào thể nhận; (ii) Kích thước của đoạn DNA được biến nạp; và (iii) Nồng độ của DNA.
Cơ chế phân tử của biến nạp (trong thí nghiệm Griffith), về cơ bản, có thể giải thích như sau:
(i) DNA sợi kép tế bào vi khuẩn cho S xâm nhập qua màng tế bào vi khuẩn nhận R, với một sợi đơn bị phân huỷ bởi nuclease;
(ii) DNA thể nhận R biến tính ở vùng tương đồng để bắt cặp hay tiếp hợp (synapsis) với đoạn DNA sợi đơn còn lại của thể cho S. Để có thể tái tổ hợp bình thường ở vi khuẩn cần có protein được mã hoá bởi gene recA+.
(iii) Phân tử DNA với đoạn lai (heteroduplex) "R-S" tái bản tạo ra hai DNA sợi kép con: một sợi kép "R-R" và một sợi kép khác có mang đoạn DNA thể nhận "S-S", tất cả có hai sợi đơn giống nhau (homoduplex).
Từ thí nghiệm của Avery và cs, ta thấy rằng: Mặc dù thành phần hoá học của vỏ vi khuẩn (capsule) được xác định bằng các gene, nhưng mối quan hệ đó là gián tiếp. DNA được phiên mã thành RNA và RNA được dịch mã thành các protein. Kiểu hình của pneumococcus — thành phần của vỏ polysaccharide — được xác định bằng các enzyme (proteins) cụ thể (dùng để tổng hợp polysaccharide).
Xác định liên kết gene bằng biến nạp
Trong quá trình tách chiết DNA để tiến hành biến nạp, nhiếm sắc thể của vi
khuẩn thường bị đứt ra thành khoảng 250 đoạn, tức các phân tử riêng biệt. Các gene nằm ở những vị trí khác nhau trên nhiễm sắc thể vi khuẩn khi đó sẽ bị tách rời nhau và được truyền đi trong quá trình biến nạp một cách độc lập. Vì số gene ở vi khuẩn rất lớn mà số đoạn DNA lại hạn chế nên không loại trừ các trường hợp hai gene khác nhau cùng nằm trên một đoạn DNA, và vì vậy, cùng được chuyển đi. Trên thực tế những trường hợp như thế đã quan sát thấy ở hàng loạt vi khuẩn và gọi là biến nạp liên kết. Có thể phát hiện được biến nạp liên kết bằng cách xác định tần số biến nạp kép (biến nạp đồng thời hai gene, hay đồng biến nạp, cotransformed) và so sánh nó với trị số kỳ vọng khi hai gene được truyền đi một cách độc lập. Trong thí nghiệm người ta xác định sự liên kết gene bằng cách phát hiện hiệu quả pha loãng DNA. Trong một giới hạn nào đó của nồng độ DNA thì tần số biến nạp tỉ lệ tuyến tính với nồng độ DNA. Nếu hai gene nằm trên cùng một đoạn DNA thì sự biến đổi tần số biến nạp kép (liên kết) sẽ giống như biến nạp đơn. Còn nếu như biến nạp kép là do hai đoạn DNA khác nhau cùng chui vào tế bào (không liên kết) thì đường cong biến đổi của tần số biến nạp kép sẽ có độ dốc rõ rệt hơn so với biến nạp đơn.
Biến nạp chỉ được dùng để lập bản đồ gene cho một số loài. DNA thể cho được tách ra và làm đứt gãy thành những đoạn nhỏ. Đối với những tế bào khả biến, tần số biến nạp khoảng 1/ 103 tế bào. Nếu hai gene a và b xa nhau trên nhiễm sắc thể thì nó thường nằm ở 2 đoạn bị đứt ra khác nhau. Khi đó tần số biến nạp cả hai gene này vào thể cho sẽ khoảng 1/103 x 1/103 = 1/106. Nếu hai gene này gần nhau thì tần số đồng biến nạp của chúng xấp xỉ bằng biến nạp đơn: 1/103. Nghiên cứu khả năng đi kèm nhau của các gene biến nạp có thể xác định được trật tự của chúng.
III. Tiếp hợp ở vi khuẩn (Conjugation)
1. Định nghĩa, thí nghiệm và đặc điểm chung
Định nghĩa: Tiếp hợp là hiện tượng tiếp xúc trực tiếp giữa hai tế bào vi khuẩn và kèm theo việc truyền một phần vật chất di truyền từ tế bào thể cho (donor) sang tế bào thể nhận (recipient, receptor).
(a) 
(b) 
Hình 6.4 (a) Joshua Lederberg (trái) và E.L. Tatum; (b) E. coli tiếp hợp. Hai tế bào kết hợp nhau bằng một cầu nối, thể cho bên trái và thể nhận bên phải.
Thí nghiệm: Vào năm 1946, Joshua Lederberg và E.L.Tatum (Hình 6.4) đã sử dụng các nòi đột biến khuyết dưỡng khác nhau ở E, coli để
chứng minh có tái tổ hợp giữa chúng. Cụ thể, nòi A có kiểu gene met- bio- thr+ leu+ và nòi B có kiểu gene ngược lại, met+ bio+ thr- leu-. Nếu đem nuôi cấy riêng rẽ trên các môi trường tối thiểu, các nòi này không sinh trưởng được. Tuy nhiên sau khi trộn lẫn hai nòi A và B trong ống nghiệm và đem cấy lên môi trường tối thiểu, thấy có xuất hiện các khuẩn lạc. Điều đó chứng tỏ có sự tái tổ hợp giữa hai nòi và làm xuất hiện dạng lai hay các thể tái tổ hợp, với kiểu gene met+ bio+ thr+ leu+, bù đắp sự khiếm khuyết cho nhau trong nhu cầu dinh dưỡng (Hình 6.5).
(a) Nòi A Nòi B
met- bio- thr+ leu+ met+ bio+ thr- leu-
2 x 108 tế bào 1 x 108 tế bào 1 x 108 tế bào 2 x 108 tế bào
------------Môi trường tối thiểu --------------
Không mọc met+ bio+ thr+ leu+ Không mọc (các thể tái tổ hợp)
(b)
Nòi A:met- bio- thr+eu+ met+ bio+ thr+ leu+
+
Nòi B: met+ bio+ thr-l eu- met- bio- hr+ leu+
(các thể tái tổ hợp)
Hình 6.5 Thí nghiệm kinh điển về tái tổ hợp ở vi khuẩn. (a) Hai nòi khuyết dưỡng A và B được hỗn hợp với nhau. Mỗi nòi tự nó không thể mọc được trên trên môi trưởng tối thiểu, nhưng khi hỗn hợp hai nòi làm xuất hiện các thể tái tổ hợp có thể mọc được trên môi trường tối thiểu, cho các khuẩn lạc mọc trên đĩa petri ở giữa. (b) Sự kiện tái tổ hợp làm sản sinh các thể nguyên dưỡng. Một trao đổi chéo xảy ra giữa các gene bio và thr đem các allele kiểu dại về một nhiễm sắc thể và các allele đột biến trên nhiễm sắc thể kia.
Như vậy, theo hiểu biết sau này ta có thể hình dung một số vi khuẩn, ví dụ E. coli, có thể truyền một phần nhiễm sắc thể của chúng cho thể nhận mà chúng tiếp xúc trực tiếp. Khi thể cho tái bản nhiễm sắc thể của nó thì bản sao được tiêm vào thể nhận. Tại thời điểm bất kỳ thể cho và thể nhận tách khỏi nhau thì việc truyền gene dừng lại. Các gene thực hiện "chuyến du hành" thành công sẽ thay chỗ tương đương trong nhiễm sắc thể của thể nhận. DNA được truyền gồm một bộ các gene nằm kề nhau gọi






